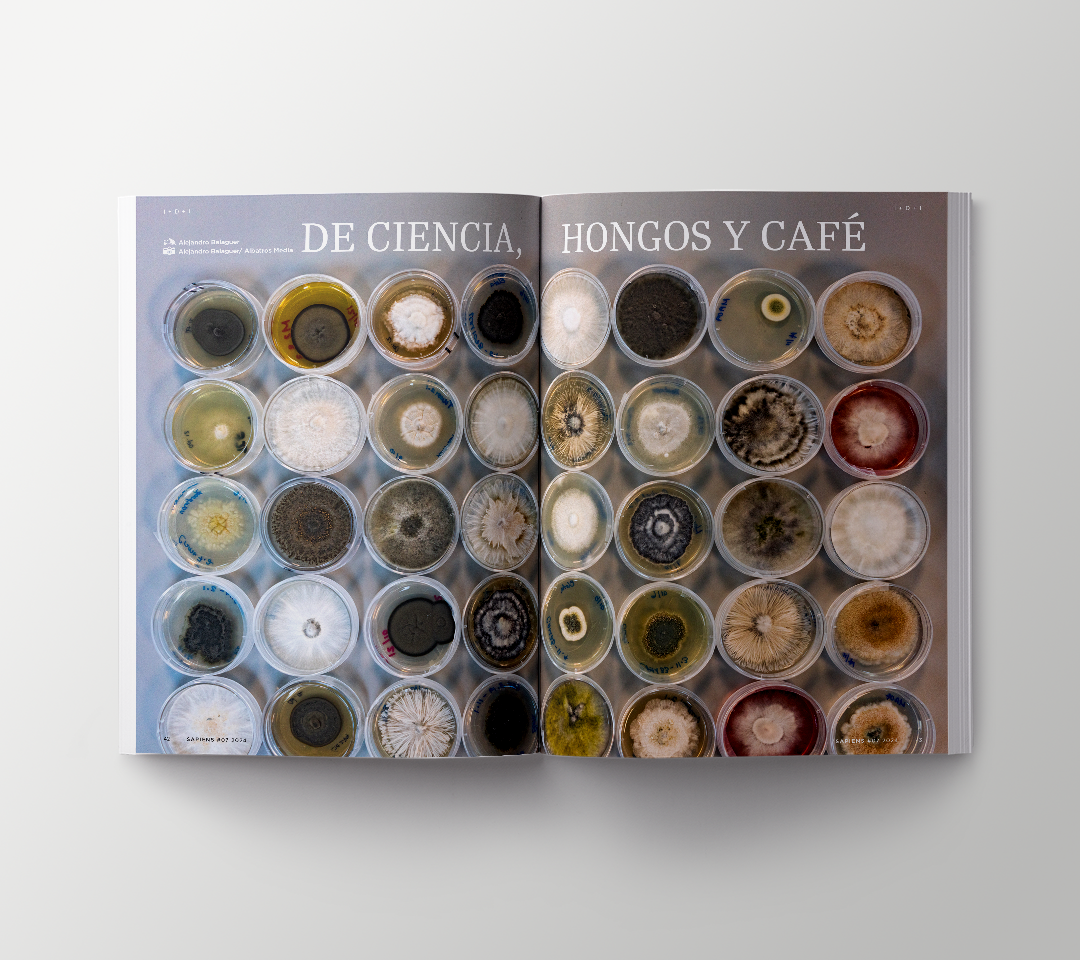

Diseño de la revista Sapiens #07 de Ciudad del Saber, edición de diciembre 2024.
Fotografía de Portada: Alexandra César
En portada: Dra. Julia Mayo Torné, arqueóloga e investigadora panameña-española. Directora del Proyecto Arqueológico El Caño.
Textos: Esther Pang, Anayansi Chichaco, Luz Bonadies, Alejandro Balaguer, Amalia Aguilar Nicolau, Cristina Collazos, Raúl Altamar Arias, Larú Linares, Edith Castillo Núñez y Juan Frochaux.
Fotografías: Ricardo Kirsch, Ana M. Fajardo, Frank Málaga, Sebastián Icaza, Ismael Guenoun Sanz, Emma Constantini, Alejandro Balaguer, Alexandra César, Gustavo Araújo, Abner Benaim, AcáEsVisual, Freepik, Alamy; y cortesía de Vicente Pascual, Fundación El Caño, SENACYT y UNFPA.
Editora general: Mariana Núñez Haugland
Coordinadora editorial: Nicole Loré
Dirección de arte: Lorena Carrasco
Asesores editoriales: Luz Bonadies, Guillermo Castro y Walo Araújo
Consejo Editorial: Gabrielle B. Britton - INDICASAT, Harry Brown Araúz - CIEPS, José Ramón Padilla - IESA, Alejandro Balaguer - Fundación Albatros Media.
Impresión: Monograma Estudio de Impresión